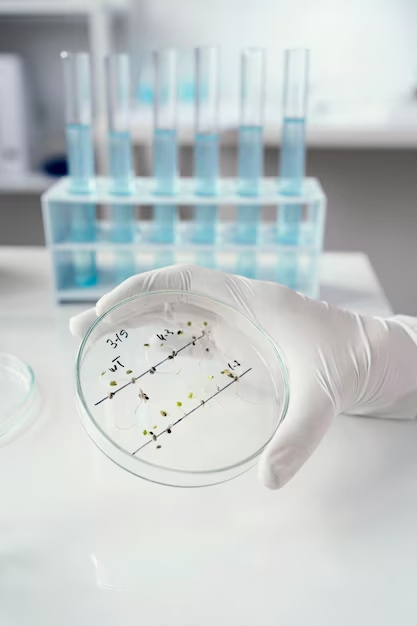
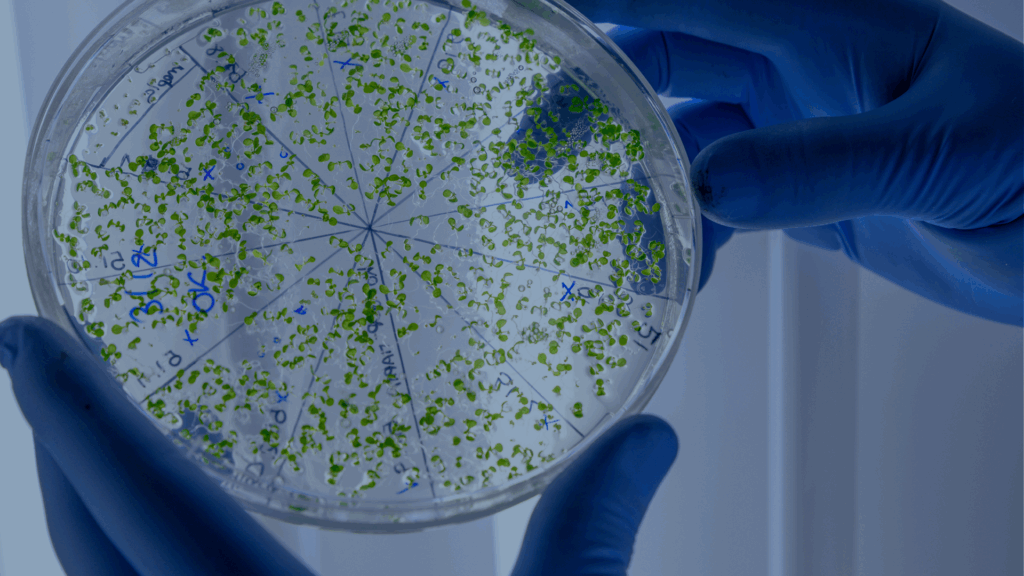
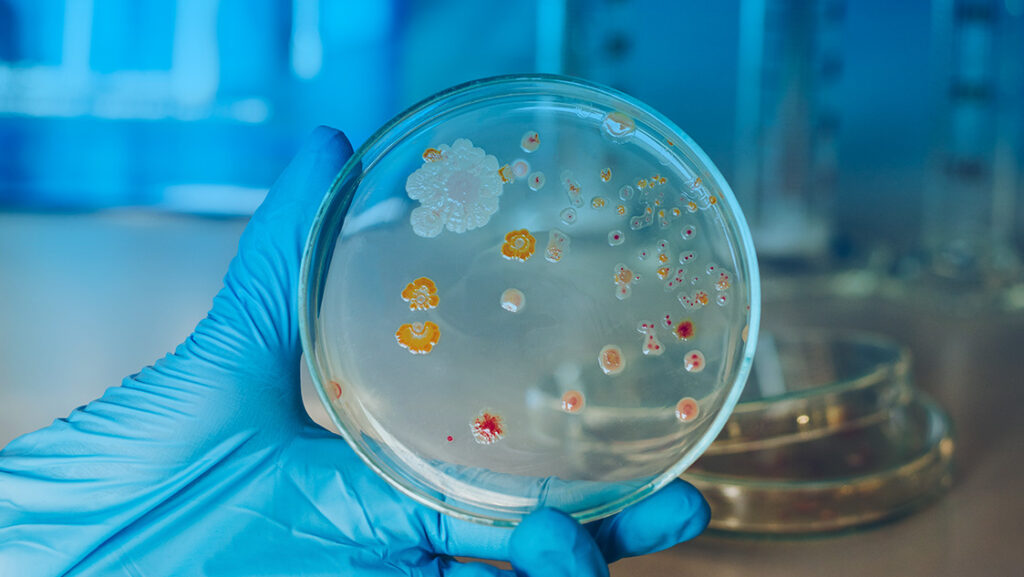
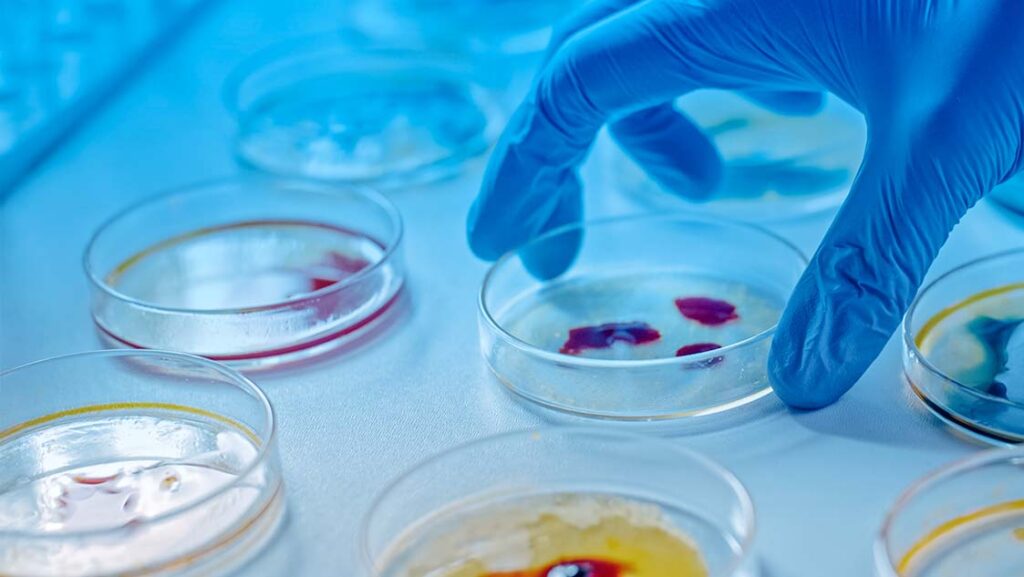
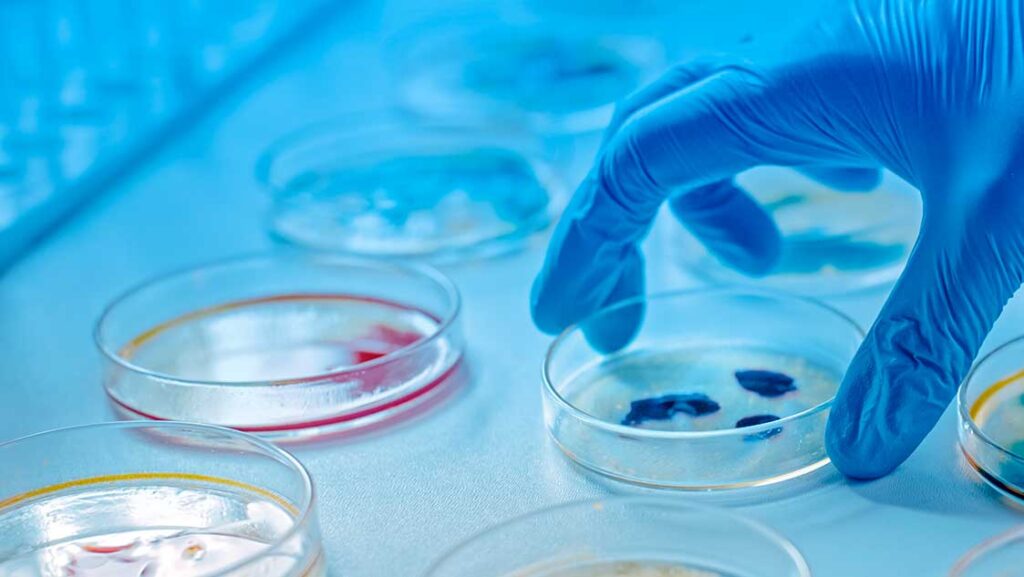

Soluções Life Sciences GVS
Ferramentas de pesquisa para filtração, blotting de proteínas e de ácidos nucléicos e transferência.
Produtos Life Sciences

Há mais de 35 anos, a GVS se concentra na inovação de sua gama de produtos e processos de produção, melhorando constantemente sua qualidade e capacidade de desenvolvimento para oferecer os melhores serviços e suporte aos seus clientes.

BLOG Life Sciences GVS
Produtos Livres de PFAS: segurança analítica, sustentabilidade e alta performance para laboratórios de Life Sciences
Produtos Livres de PFAS: segurança analítica, sustentabilidade e alta performance para laboratórios de Life Sciences…
Microcarreadores para Cultura Celular da GVS: alta performance com Microcarreador em Flocos e Microcarreador Esférico
Microcarreadores para Cultura Celular da GVS: alta performance com Microcarreador em Flocos e Microcarreador Esférico…
Flame Fast da GVS: uma Nova Era em análises de água com um Kit qPCR Tudo-em-Um
Flame Fast da GVS: uma Nova Era em análises de água com um Kit qPCR…
Filtro de Ventilação de 50mm para Biorreatores de Bancada: alta performance com estoque nacional
Filtro de Ventilação de 50mm para Biorreatores de Bancada: alta performance com estoque nacional A…
Filtros Cartflow PTFE 0,22µm da GVS: a solução de alta performance para ventilação de ar em biorreatores com estoque nacional
Filtros Cartflow PTFE 0,22µm da GVS: a solução de alta performance para ventilação de ar…
Frascos de Cultura com Agitador da GVS: eficiência superior para cultura de células e microcarreadores em laboratórios de Life Sciences
Frascos de Cultura com Agitador da GVS: eficiência superior para cultura de células e microcarreadores…
Carboy Bottle da GVS: garrafão técnico para armazenamento estéril e cultura de células com máxima segurança e versatilidade
Carboy Bottle da GVS: garrafão técnico para armazenamento estéril e cultura de células com máxima…
Colunas HPLC: tecnologia, precisão e confiabilidade para análises em Life Sciences
Colunas HPLC: tecnologia, precisão e confiabilidade para análises em Life Sciences As Colunas HPLC (High…
Tubos de Biorreação da GVS: eficiência e confiabilidade para cultivo celular e otimização de processos biológicos
Tubos de Biorreação da GVS: eficiência e confiabilidade para cultivo celular e otimização de processos…
Swabs de Esponja da GVS: precisão, segurança e eficiência na detecção microbiana
Swabs de Esponja da GVS: precisão, segurança e eficiência na detecção microbiana A análise microbiológica…
Filtros Centrífugos GVS:Precisão, Rapidez e Confiabilidade na Preparação de Amostras Biológicas
Filtros Centrífugos GVS:Precisão, Rapidez e Confiabilidade na Preparação de Amostras Biológicas A preparação de amostras…
Sacos de Amostragem GVS: Segurança, Esterilidade e Eficiência na Coleta de Amostras
Sacos de Amostragem GVS:Segurança, Esterilidade e Eficiência na Coleta de Amostras Garantia de integridade e…
Filtro sem Seringa SEPARA® Livre de PFAS GVS: precisão e sustentabilidade para a indústria Life Sciences
Filtro sem Seringa SEPARA® Livre de PFAS GVS: precisão e sustentabilidade para a indústria Life…
Filtro de Seringa ABLUO® SUPREME GVS: tecnologia exclusiva de tripla camada para amostras de difícil filtração
Filtro de Seringa ABLUO® SUPREME GVS:Tecnologia exclusiva de tripla camada para amostras de difícil filtração…
MicroPad GVS: Tecnologia PRONTA PARA USO que transforma o controle microbiológico na indústria alimentícia
MicroPad GVS: Tecnologia PRONTA PARA USO que transforma o controle microbiológico na indústria alimentícia A…
Lançamento GVS: Produtos Livres de PFAS, inovação sustentável para o futuro da filtração
Lançamento GVS: Produtos Livres de PFAS, inovação sustentável para o futuro da filtração A GVS…
CellWell GVS: A Solução Inovadora para Cultura de Células
CellWell GVS: A solução inovadora para cultura de células No universo da pesquisa e experimentação…
MicroPad: A Revolução na Contagem Microbiana com Resultados Rápidos e Confiáveis
MicroPad A revolução na contagem microbiana com resultados rápidos e confiáveis A segurança alimentar é…
FLAME Filler: tecnologia para manuseio de líquidos com precisão e ergonomia!
FLAME Filler: tecnologia para manuseio de líquidos com precisão e ergonomia! O FLAME Filler é…
Pipeta Eletrônica Automática GVS: Precisão e Eficiência no Manuseio de Líquidos para Life Sciences
Pipeta Eletrônica Automática GVS:Precisão e eficiência no manuseio de líquidos para Life Sciences Descubra como…
Filtros de Seringa 33mm ABLUO da GVS: Eficiência, Versatilidade e Qualidade na Preparação de Amostras
Filtros de Seringa 33mm ABLUO da GVS:Eficiência, versatilidade e qualidade na preparação de amostras Precisão…
Borbulhadores e Difusores de Ar Sinterizados da GVS: A Solução Eficiente para Aeração na Indústria
Borbulhadores e Difusores de Ar Sinterizados da GVS:A solução eficiente para aeração na indústria Aeração…
Membranas de Transferência para Western Blotting da GVS: Alta Performance para Resultados Confiáveis em Imunodetecção
Membranas de Transferência para Western Blotting da GVS:Alta performance para resultados confiáveis em imunodetecção Você…
Colunas HPLC da GVS: Precisão, Eficiência e Versatilidade para Análises Cromatográficas de Alto Desempenho
Colunas HPLC da GVS: Precisão, eficiência e versatilidade para análises cromatográficas de alto desempenho A…
Fibra Flow: Solução Avançada em Filtração de Fluxo Tangencial para a Indústria Life Sciences
Fibra Flow: solução avançada em filtraçãode fluxo tangencial para a indústria Life Sciences A filtração…
Sterilo – Unidades de Testes MicrobianosPrecisão e Confiabilidade em Testes Microbianos na Área de Life Sciences
Sterilo: unidades de testes microbianos precisão e confiabilidade em testes microbianos na área de Life…
Cartucho SPE para Cromatografia: A Solução Ideal para Purificação e Análise de Amostras
Cartucho SPE para Cromatografia:A solução ideal para purificação e análise de amostras No mundo das…
Filtros Sem Seringa SEPARA® da GVS: economize tempo e dinheiro na filtração de amostras
Filtros sem Seringa SEPARA® da GVS:Economize tempo e dinheiro na filtração de amostras Profissionais que…
Flame Filler da GVS: o pipetador automático que revoluciona a pipetagem em laboratórios
Flame Filler da GVS: o pipetador automático que revoluciona a pipetagem em laboratórios A pipetagem…
Filtro de Ventilação de 50 mm da GVS: a solução ideal para ventilação estéril e filtração de gases
Filtro de Ventilação de 50 mm da GVS: a solução ideal para ventilação estéril e…
Filtro de Seringa ABLUO SUPREME da GVS: elimine impurezas e economize tempo
Filtro de Seringa ABLUO SUPREME da GVS:Elimine impurezas e economize tempo Em laboratórios e ambientes…
Filtros Cânula para Dissolutores GVS: Precisão e Eficiência na Preparação de Amostras de Dissolução
Filtros Cânula para Dissolutores GVS:Precisão e eficiência na preparação de amostras de dissolução Garanta precisão…
Sistema de Filtração 47 mm Polissulfona GVS: Solução Eficiente para Filtração Asséptica
Sistema de Filtração 47 mm Polissulfona GVS:Solução eficiente para filtração asséptica A filtração de líquidos…
Conheça os benefícios da solução GVS para armazenamento e transporte de fluidos
Conheça os benefícios da solução GVS para armazenamento e transporte de fluidos Conheça agora as…
3 características essenciais em um fornecedor confiável de insumos para biorreatores!
3 características essenciais em um fornecedor confiável de insumos para biorreatores! Entenda como identificar e…
Filtro hidrofóbico: por que essa característica é essencial em sistemas de ventilação estéril?
Filtro hidrofóbico: por que essa característica é essencial em sistemas de ventilação estéril? Conheça os…
Etapas para alcançar a excelência no seu sistema de gerenciamento de qualidade em bioprocessos
Etapas para alcançar a excelência no seu sistema de gerenciamento de qualidade em bioprocessos Confira as etapas…
Membrana de fibra oca: descubra o que é e como funciona, com a tecnologia inovadora GVS
Membrana de fibra oca: descubra o que é e como funciona, com a tecnologia inovadora…
Descubra porque a GVS é a sua melhor escolha em produtos para indústria farmacêutica!
Descubra porque a GVS é a sua melhor escolha em produtos para indústria farmacêutica! Oferecendo…
Veja como a GVS está transformando o mercado de bioprocessos com soluções de excelência
Veja como a GVS está transformando o mercado de bioprocessos com soluções de excelência O…
Potencialize sua produção: conheça todos os benefícios da microfiltração tangencial da GVS!
Potencialize sua produção: conheça todos os benefícios da microfiltração tangencial da GVS! Neste texto você…
Biotecnologia Industrial: saiba como as soluções da GVS podem elevar a sua produção!
Biotecnologia Industrial: saiba como as soluções da GVS podem elevar a sua produção! A biotecnologia…
3 dicas para aprimorar o seu processo de purificação de proteínas!
3 dicas para aprimorar o seu processo de purificação de proteínas! A purificação de proteínas…
Garrafas para cultura de células: por que é tão importante ter as ferramentas adequadas?
Garrafas para cultura de células: por que é tão importante ter as ferramentas adequadas? Descubra…
Ciência biomédica: o que é necessário para fazer uma pesquisa acadêmica?
Ciência biomédica: o que é necessário para fazer uma pesquisa acadêmica? Descubra o passo a…
Cultura de célula: desenvolva a sua pesquisa com os melhores produtos do mercado
Cultura de célula: desenvolva a sua pesquisa com os melhores produtos do mercado Garanta as…
Saiba quais são as ferramentas avançadas para a cultura de células na ciência biomédica
Saiba quais são as ferramentas avançadas para a cultura de células na ciência biomédica Tenha…
Produtos para biologia celular e molecular: conheça a linha completa!
Produtos para biologia celular e molecular: conheça a linha completa! As soluções mais adequadas para…
Biologia celular e molecular: qual é a diferença entre enzima e catalisador?
Biologia celular e molecular: qual é a diferença entre enzima e catalisador? Saiba tudo o…
Estudo in vitro: 5 vantagens de testes em processos farmacêuticos
Estudo in vitro: 5 vantagens de testes em processos farmacêuticos Veja como estudos laboratoriais podem…
A importância de uma Placa de Petri para o estudo de cultura de células
A importância de uma Placa de Petri para o estudo de cultura de células Aprenda…
Descubra quais são as ferramentas apropriadas para estudo in vitro
Descubra quais são as ferramentas apropriadas para estudo in vitro Tudo o que você precisa…
Placa de Petri: como armazenar e cuidar para garantir a qualidade da pesquisa
Placa de Petri: como armazenar e cuidar para garantir a qualidade da pesquisa Dicas e…
A técnica de cultivo celular: tipos de cultura e equipamentos para pesquisa
A técnica de cultivo celular: tipos de cultura e equipamentos para pesquisa Conheça todas as…
Cultivo celular: descubra ferramentas que acompanham qualidade e o menor preço
Cultivo celular: descubra ferramentas que acompanham qualidade e o menor preço Realize uma pesquisa sem…
Filtração qualitativa e quantitativa: entenda a diferença
Filtração qualitativa e quantitativa: entenda a diferença Veja como esses métodos são aplicados na indústria…
Controle de qualidade: como é aplicado na indústria farmacêutica?
Controle de qualidade: como é aplicado na indústria farmacêutica? Descubra o que determina a lei…
Controle microbiológico: entenda a importância para a indústria alimentícia
Controle microbiológico: entenda a importânciapara a indústria alimentícia Veja como evitar contaminação cruzada durante as…
HACCP: entenda como o método pode melhorar a qualidade dos alimentos produzidos na sua empresa
HACCP: entenda como o método podemelhorar a qualidade dos alimentos produzidos na sua empresa Veja…
Filtros para indústria farmacêutica: conheça itens de baixo custo que prometem agilizar sua produção!
Filtros para indústria farmacêutica: conheça itens de baixo custo que prometem agilizar sua produção! As…
Membrana Polietersulfona: a melhor opção para esterilização e filtração!
Membrana Polietersulfona: a melhor opção para esterilização e filtração! Conheça opções de membrana que mudarão…
Capsflow: veja como evitar a contaminação cruzada, com os filtros ideais
Capsflow: veja como evitar a contaminação cruzada, com os filtros ideais Realize todos os processos…
Filtro de alta vazão: veja os mais qualificados no mercado!
Filtro de alta vazão: veja os mais qualificados no mercado! Entenda como a escolha correta…
Microfiltração na indústria farmacêutica: veja como funciona!
Microfiltração na indústria farmacêutica: veja como funciona! Você sabe como utilizar um filtro em processos farmacêuticos?…
Entenda como funciona uma microfiltração por membranas
Entenda como funciona uma microfiltração por membranas Saiba tudo sobre esse processo e as vantagens…
Filtro descartável x reutilizável: qual é o mais adequado para a sua empresa?
Filtro descartável x reutilizável: qual é o mais adequado para a sua empresa? Entenda como…
Membrana hidrofílica x hidrofóbica: como posso usá-las na filtração?
Membrana hidrofílica x hidrofóbica: como posso usá-las na filtração? Veja a diferença entre cada tipo…
Saiba quais são os processos que utilizam filtros industriais
Saiba quais são os processos que utilizam filtros industriais Entenda como a filtração pode ser trabalhada…
Cartflow: o filtro ideal para os processos da indústria farmacêutica
Cartflow: o filtro ideal para os processos da indústria farmacêutica Filtros de cartucho que atuam…
Filtração em aplicação biofarmacêutica: entenda como funciona!
Filtração em aplicação biofarmacêutica: Entenda como funciona! Entenda os métodos que uma empresa biofarmacêutica utiliza…
Contaminação microbiológica: conheça suas principais ameaças
Contaminação microbiológica: conheça suas principais ameaças Veja como evitar os danos que certas bactérias podem…
O que é ultrafiltração e quais são os seus benefícios?
O que é ultrafiltração e quais são os seus benefícios? Entenda como é feito o…
Membrana filtrante: como escolher a melhor opção do material?
Membrana filtrante: como escolher a melhor opção do material? Descubra o que analisar ao realizar…
Como é realizado o processo de filtração por membrana?
Como é realizado o processo de filtração por membrana? Entenda como funciona, as etapas e…
Membrana filtrante: conheça os itens essenciais para o tratamento de água
Membrana filtrante: conheça os itens essenciais para o tratamento de água Utilize as melhores opções…
Filtração industrial: entenda como executá-la da melhor forma!
Filtração industrial: entenda como executá-la da melhor forma! Confiras as boas práticas para o processo…
Substrato ECL: saiba o que é, e a sua principal função
Substrato ECL: saiba o que é, e a sua principal função Aprenda o que faz…
Monitores microbiológicos: saiba como encontraro ideal para a sua empresa
Monitores microbiológicos: saiba como encontrar o ideal para a sua empresa Descubra quais são os…
Membrana PCTE e o processo de extrusão de lipossomas
Membrana PCTE e o processo de extrusão de lipossomas Entenda como esse componente é aplicado…
Biologia molecular industrial: você sabe como essas técnicas são aplicadas?
Biologia molecular industrial: você sabe como essas técnicas são aplicadas? Entenda a importância do processo…
Filtros de seringa: Você sabe em quais situações aplicados?
Filtros de seringa: Você sabe em quais situações são aplicados? Descubra as principais aplicações e…
Veja como um filtro com cartucho plissado pode reter as menores partículas
Veja como um filtro com cartucho plissado pode reter as menores partículas Entenda os atributos…
Biofermentação: saiba como o processo é realizado
Biofermentação: saiba como o processo é realizado Descubra como funciona a fermentação e qual a…
Western Blotting: saiba tudo sobre as etapas desse teste
Western Blotting: saiba tudo sobre as etapas desse teste Descubra o passo a passo desse…
Extração de DNA e RNA: saiba como é realizada
Extração de DNA e RNA: saiba como é realizada Descubra como o procedimento é feito,…
Cultivo celular: descubra a importância da filtração no processo
Cultivo celular: descubra a importância da filtração no processo Saiba como é realizado o procedimento…
Análise microbiológica: descubra a importância de escolher a membrana correta
Análise microbiológica: descubra a importância de escolher a membrana correta Conheça algumas ações fundamentais para…
Redução de custos: saiba como otimizar o seu laboratório
Redução de custos: saiba como otimizar o seu laboratório Descubra como implementar métodos de redução…
Meios de cultura: entenda a importância para a microbiologia
Meios de cultura: entenda a importância para a microbiologia Descubra como funcionam os meios de…
Boas práticas de laboratório: como manter o melhor ambiente
Boas práticas de laboratório: como manter o melhor ambiente Conheça algumas ações fundamentais para o…
Partículas finas: riscos, soluções e tudo o que você precisa saber sobre o assunto
Partículas finas: riscos, soluções e tudo o que você precisa saber sobre o assunto Veja…
Microfiltração, nanofiltração e ultrafiltração: descubra as diferenças entre os processos
Microfiltração, nanofiltração e ultrafiltração: Descubra as diferenças entre os processos Veja, também, como funciona o…
Microbiologia dos alimentos: tudo o que você precisa saber sobre o processo
Microbiologia dos alimentos: tudo o que você precisa saber sobre o processo Conheça membranas que…
Processos de Separação por Membrana: microfiltração para lácteos
Processos de Separação por Membrana: Microfiltração para lácteos Entenda como a tecnologia dos processos de…
O que é segurança alimentar e segurança do alimento
O que é segurança alimentar e segurança do alimento Entenda porquê segurança alimentar é tão…
Descubra a importância da filtração no preparo de amostras cromatográficas
Descubra a importância da filtração no preparo de amostras cromatográficas Entenda como o processo funciona…
A importância da microbiologia de alimentos na qualidade dos produtos
A importância da microbiologia de alimentos na qualidade dos produtos Veja como ela pode fazer…
Entenda tudo o que você precisa sobre o Codex Alimentarius
Entenda tudo o que você precisa sobre o Codex Alimentarius Conheça mais sobre esse importante…
O passo a passo para criar um Manual de Boas Práticas de Fabricação na indústria alimentícia
O passo a passo para criar um Manual deBoas Práticas de Fabricação na indústria alimentícia…